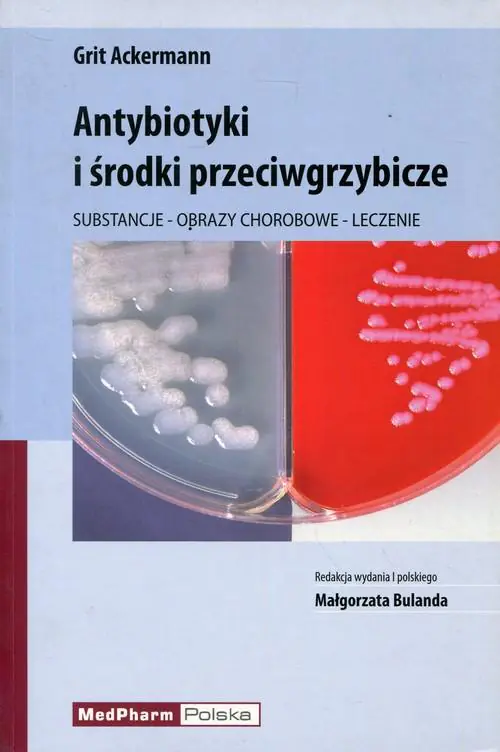
Książka - Antybiotyki i środki przeciwgrzybicze. Substancje - obrazy chorobowe - leczenie

Stan książek
Nasze książki są dokładnie sprawdzone i jasno określamy stan każdej z nich.






Nowa
Książka nowa.





Używany - jak nowa
Niezauważalne lub prawie niezauważalne ślady używania. Książkę ciężko odróżnić od nowej pozycji.





Używany - dobry
Normalne ślady używania wynikające z kartkowania podczas czytania, brak większych uszkodzeń lub zagięć.





Używany - widoczne ślady użytkowania
zagięte rogi, przyniszczona okładka, książka posiada wszystkie strony.
Antybiotyki i środki przeciwgrzybicze. Substancje - obrazy chorobowe - leczenie
Masz tę lub inne książki?
Sprzedaj je u nas
Prawidłowe zarządzanie terapią antybiotykową wymaga specjalistycznej wiedzy oraz odpowiedniego doświadczenia, aby leczenie było efektywne, przystępne cenowo i dobrze tolerowane przez pacjenta. Ta książka dostarcza kompleksowej wiedzy na temat antybiotyków, jak również leków przeciwgrzybiczych i przeciwgruźliczych.
Czytelnicy znajdą w niej szczegółowe informacje dotyczące farmakokinetyki i dawkowania leków, z uwzględnieniem pacjentów z chorobami nerek. Ponadto, książka oferuje schematy terapii zastępczej dla różnych infekcji oraz analizuje zakres działania leków i profile oporności bakterii na antybiotyki.
Publikacja ta stanowi doskonałe wsparcie i uzupełnienie obecnej wiedzy dla praktykujących lekarzy, studentów medycyny oraz farmaceutów, stanowiąc cenne źródło informacji w ich codziennej pracy.
Wybierz stan zużycia:
WIĘCEJ O SKALI
Prawidłowe zarządzanie terapią antybiotykową wymaga specjalistycznej wiedzy oraz odpowiedniego doświadczenia, aby leczenie było efektywne, przystępne cenowo i dobrze tolerowane przez pacjenta. Ta książka dostarcza kompleksowej wiedzy na temat antybiotyków, jak również leków przeciwgrzybiczych i przeciwgruźliczych.
Czytelnicy znajdą w niej szczegółowe informacje dotyczące farmakokinetyki i dawkowania leków, z uwzględnieniem pacjentów z chorobami nerek. Ponadto, książka oferuje schematy terapii zastępczej dla różnych infekcji oraz analizuje zakres działania leków i profile oporności bakterii na antybiotyki.
Publikacja ta stanowi doskonałe wsparcie i uzupełnienie obecnej wiedzy dla praktykujących lekarzy, studentów medycyny oraz farmaceutów, stanowiąc cenne źródło informacji w ich codziennej pracy.














